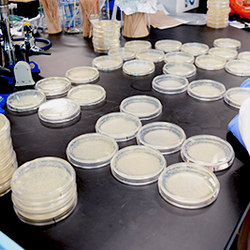
petridishes

Welcome to the Department of Microbiology and Plant Pathology
Located at the University of California, Riverside

CNAS Scholarships
CNAS Student Scholarships are open. Apply now!
The deadline is May 1, 2026.
The deadline is May 1, 2026.

Microbiology
Faculty in the department work on research areas such as Bacteriology, Microbial Pathogenesis, Environmental Microbiology and Ecology, Microbiome, Microbial Genomics and more.

Citrus Research
With a disease such as Huanglongbing also known as citrus greening disease affecting trees in Florida and Calfornia, plant pathologists in the Department of Microbiology and Plant Pathology are at the forefront in research to find a way to combat this disease.

Show your support
Your generous gift helps support two graduate programs, an undergraduate major, and research in 22 laboratories.